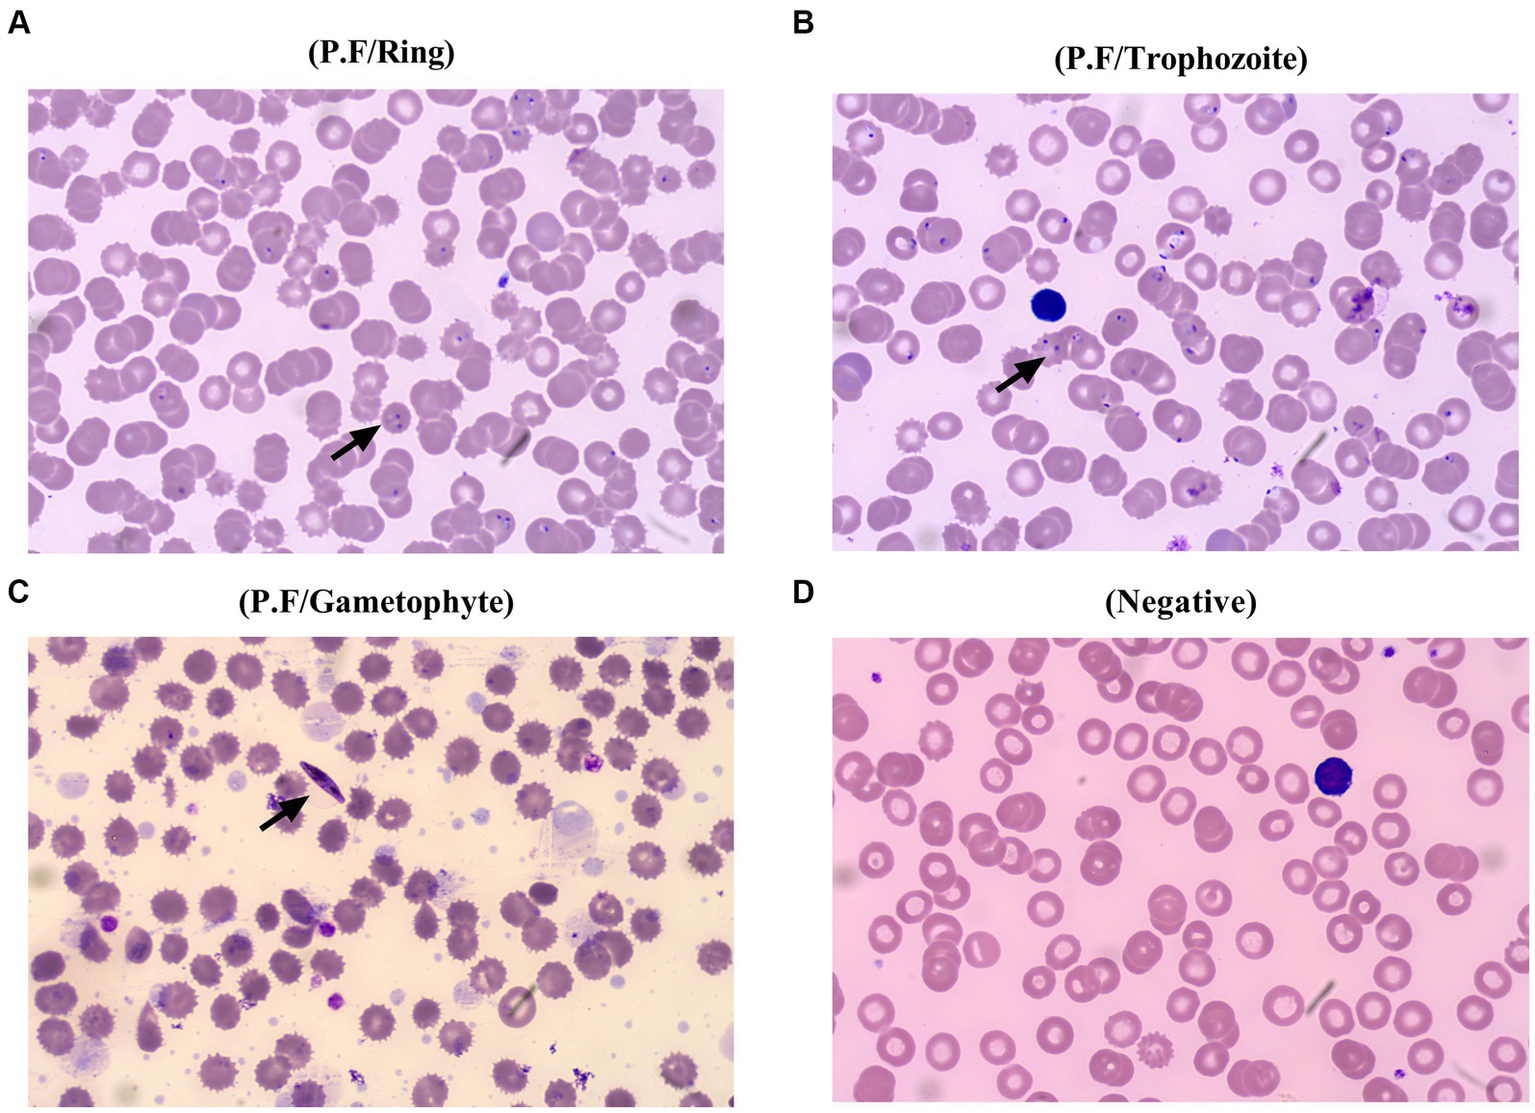

Abstract
Background:
Hemorrhagic fever with renal syndrome (HFRS) is a natural epidemic disease that can be caused by the Hantaan virus (HTNV). Malaria is caused by plasmodium and can be transmitted by a mosquito bite. The similar manifestations shared by these disorders pose a challenge for clinicians in differential diagnosis, in particular, coupled with a false-positive serological test.
Case presentation:
A 46-year-old man was admitted for fever and chills for over 10 days and was suspected of being co-infected with HFRS and malaria due to a history of travel to malaria-endemic areas and a positive HTNV-immunoglobulin M (IgM) test. Although leukocytosis, thrombocytopenia, renal injury, lymphocytosis, overexpression of interleukin-6, and procalcitonin were observed during the hospitalization, the hypotensive, oliguria, and polyuria phases of the HFRS course were not observed. Instead, typical symptoms of malaria were found, including a progressive decrease in erythrocytes and hemoglobin levels with signs of anemia. Furthermore, because the patient had no history of exposure to HFRS endemic areas, exposure to an HTNV-infected rodent, or a positive HTNV-IgG test, and false serological tests of IgM can be caused by various factors, the HFRS coinfection with malaria was ruled out.
Conclusion:
Misdiagnosis can be easily induced by a false serological test, in particular the IgM test which can be influenced by various factors. A combination of health history, epidemiology, physical examination, precise application of specific examinations involving tests of conventional laboratory parameters as well as well-accepted methods such as the immunochromatographic (ICG) test, real-time reverse transcription-polymerase chain reaction (PCR), and Western blot (WB), and acquaintance with disorders with similar manifestations will contribute to the precise diagnosis in clinical treatment.
1 Introduction
Hemorrhagic fever with renal syndrome (HFRS), an infectious disease caused by the Hantaan virus (HTNV), has been reported in China since the first millennium and was suggested or mentioned during the American Civil War (1862–1863) and Korea, Manchuria, and Far Eastern Russia (1913–1914), respectively (1). Thereafter, the causative agent of this disorder was recognized in Korea in 1978. Annually, 60,000–150,000 cases are registered around the world, 90% of which are reported in China. The major manifestations of HFRS are characterized by fever, hemorrhage, renal impairment, and thrombocytopenia (2). Malaria, which is caused by the plasmodium, is also associated with fever, anemia, classic paroxysm, acute renal injury, and thrombocytopenia, despite the latter being uncommon (3). Actually, malaria is also an ancient human infectious disease that has been mentioned as early as 2,700 BC in Egypt and China. Approximately, 300–500 million individuals are infected by plasmodium, with a fatal number of 1.5–2.7 million every year (4). Noteworthy, considering that the disorders aforementioned have had a profound influence on socioeconomics, public health, and the medical assistance system worldwide, substantial efforts have been made to control the prevalence of these disorders, especially the application of the inactivated monovalent and bivalent vaccines for HFRS, which has greatly reduced the morbidity of this disorder in China and Korea. Meanwhile, a recombinant protein vaccine directed against the circumsporozoite protein of malaria was reported to be in phase 3 clinical trials. Nevertheless, there is no World Health Organization (WHO)-approved vaccine to prevent HTNV and plasmodium infection worldwide (3, 5). Furthermore, given the similar symptoms possessed by these two disorders, all of which pose a challenge for clinicians in differential diagnosis and may lead to delays in effective treatment.
Here, we presented a case that is characterized by the symptoms of HFRS and malaria and confused clinicians, which may eventually lead to misdiagnosis, delays in effective treatment, or even severe outcomes for the patient. Thus, this case report provides valuable further insight for clinicians in clinical practice regarding the differential/treatment of HFRS, malaria, and the coinfection of these disorders.
2 Case presentation
A 46-year-old man was referred to the Department of Infectious Diseases of Shaanxi Provincial Hospital of Infectious Diseases (Eighth Affiliated Hospital of the Medical College of Xi’an Jiaotong University) on 7 September 2023 with a fever for more than 10 days. Two days prior to admission, he felt fatigued, had diarrhea, and was later confirmed to be infected with plasmodium coupled with a positive of HFRS-immunoglobulin M (IgM) in another medical institution. Due to the suspicion of coinfection of HFRS with malaria, he was referred to our hospital. The patient traveled to the Republic of Cameroon but has no history of health problems or other comorbidities and has not been vaccinated for the HFRS.
Physical examination on admission showed that body temperature, pulse rate, respiratory rate, and blood pressure were 38.6°C, 86 beats/min, 23 beats/min, and 110/66 mmHg, respectively, together with slight pharyngeal congestion. Laboratory examination during hospitalization indicated leukocytosis (peak value 13.15 × 109; normal value 3.7–9.15 × 109 cell/L), thrombocytopenia (nadir value 18 × 109; normal value 85–303 × 109 cell/L), and renal injury with an elevated level of creatine (Cr) (peak value 315.1; normal value 70–115 μmol/L), urea (peak value 27.1; normal value 1.7–8.3 mmol/L), and uric acid (UA) (peak value 684.2; normal value 204–416 μmol/L). Furthermore, overexpression of interleukin-6, procalcitonin, and B-type natriuretic peptide was also observed, which indicated inflammation and cardiovascular injury to some extent (Table 1). Besides, the abnormality of CD8+ T lymphocytes, B and natural killer (NK) cells were also found. Chest computer tomography (CT) scan showed a few inflammatory cords in the lower lobe of the left lung as well as the middle lobe of the right lung but with no further abnormality (Figure 1).
Table 1
| Date (day of hospitalization) | Sep. 7 (day 1) | Sep. 8 (day 2) | Sep. 9 (day 3) | Sep. 11 (day 5) | Sep. 12 (day 6) | Sep. 13 (day 7) | Sep. 14 (day 8) | Sep. 16 (day 10) | Sep. 19 (day 13) |
|---|---|---|---|---|---|---|---|---|---|
| Leukocyte (3.7–9.15 × 109/L) | 9.18 | 9.55 | 9.53 | 13.01 | 13.15 | 11.96 | 11.71 | 6.87 | |
| Neutrophile (2–7 × 109/L) | 7.36 | 7.31 | 8.51 | 11.17 | 9.98 | 7.83 | 8.46 | 4.54 | |
| Platelet (85–303 × 109/L) | 84 | 79 | 68 | 18 | 53 | 102 | 201 | 391 | |
| Erythrocytes (3.5–5.5 × 1012/L) | 4.94 | 4.62 | 4.57 | 3.95 | 3.12 | 2.98 | 2.75 | 2.48 | |
| Hemoglobin (113–151 g/L) | 150 | 142 | 138 | 116 | 93 | 88 | 80 | 73 | |
| CD3+T cell (800–4,000 cell/μL) | 910 | 1,532 | 824 | ||||||
| CD4+T cell (410–1,590 cell/μL) | 419 | 401 | 405 | ||||||
| CD8+T cell (190–1,140 cell/μL) | 222 | 1,028 | 326 | ||||||
| CD4+CD8+ T cell (0–30 cell/μL) | 6 | 5 | 3 | ||||||
| B (90–600 cell/μL) | 190 | 365 | 112 | ||||||
| NK (90–590 cell/μL) | 78 | 412 | 85 | ||||||
| APTT (24–38 s) | 34.4 | 40.4 | 36.75 | 27 | 29.59 | 38.5 | |||
| PT (10–15 s) | 13.49 | 14 | 14.33 | 10.8 | 11.53 | 12.2 | |||
| Fib (2–4 g/L) | 3.39 | 4.46 | 5.26 | 4.82 | 5.96 | 5.77 | |||
| Cr (70–115 μmol/L) | 9.46 | 130.4 | 114.4 | 218.8 | 315.1 | 296.6 | 242.3 | 178.6 | 138.9 |
| Urea (1.7–8.3 mmol/L) | 522.05 | 7.68 | 6.53 | 19.11 | 26.55 | 27.1 | 23.4 | 13.53 | 6.81 |
| UA (204–416 μmol/L) | 470.2 | 397.6 | 495.3 | 577.7 | 651.7 | 684.2 | 598.4 | 423.6 | |
| IL-6 (0–5.5 pg./mL) | 25.35 | 15.11 | 7.57 | 20.54 | |||||
| PCT (0–0.5 ng/mL) | 74.53 | 58.32 | >100 | >100 | 96.06 | 15.49 | 2.26 | ||
| BNP (≤100 ng/mL) | 41.22 | 100.21 | |||||||
| ESR (mm/h) | 43 | 150.42 | |||||||
| Proteinuria | Negative | ||||||||
| HFRS-IgM (positive/negative) | Positive | Positive | Negative | ||||||
| HFRS-IgG (positive/negative) | Negative | Negative | Negative | ||||||
| Malaria (positive/negative) | Positive | Positive | Positive | Positive | Positive | Negative | Negative | Negative | |
| Typing | P.F/Ring | P.F/Ring | P.F/Trophozoite | P.F/Trophozoite | P.F/Gametophyte | ||||
| Counting (cell/μL) | 4,600 | 45,320 | 4,200 | 4,385 | 1,002 | 0 | 0 | 0 |
Timeline of the disease course (7–19 September 2023).
NK, Natural killer cells; APTT, activated partial thromboplastin time; PT, prothrombin time; Fib, fibrinogen; Cr, creatinine; UA, uric acid; IL-6, interleukin 6; PCT, procalcitonin; BNP, B-type natriuretic peptide; ESR, erythrocyte sedimentation rate; P.F, Plasmodium falciparum.
Figure 1

Imaging characteristics of the patient. The imaging findings show a few inflammatory cords in the lower lobe of the left lung as well as the middle lobe of the right lung (A); however, the typical symptoms of HFRS, including renal edema, perirenal fascial edema, pleural effusion, and pericardial effusion, were not found (B,C).
Considering that the patient suffered a recurrent fever and chills coupled with confirmed malaria, while a typical manifestation of HFRS, including headache, orbital pain, back pain, abdominal pain, and blurred vision, was not found at admission. The patient was treated with artemether injection (100 mL/160 mg) for antimalaria together with supportive treatment including xiyampin (a traditional Chinese medicine, 250 mL/250 mg) for clearing heat and relieving cough, compound glycyrrhizin (a traditional Chinese medicine, 100 mL/120 mg) for hepatoprotection, and ranitidine (100 mL/50 mg) for the prevention of stress ulcers on admission. Although the number of infected red blood cells was significantly reduced on the fifth day of admission, the condition of the patient was still not stabilized, which presented as a progressing elevated level of procalcitonin, B-type natriuretic peptide, urea, and UA. Additionally, considering that the HFRS spectrum varies from the mild to the critical phases, non-specific flu-like symptoms can be detected in the early stages of HTNV-infected patients. Thus, the patient received treatment with a combination of methylprednisolone (100 mL/40 mg), ceftriaxone sodium (100 mL/2 g), and the aforementioned drugs since the sixth day of hospitalization. Nevertheless, owing to the deterioration of the disease course, which presented persistently elevated levels of C-reactive protein (CRP) (126.98 mg/L; normal value 0–10 mg/L) and leukocytes (13.15 × 109; normal value 3.7–9.15 × 109), the patient suffered blurred consciousness. Ceftriaxone sodium was replaced by meropenem (50 mL/0.5 g) for better anti-infection on the seventh day of hospitalization. Furthermore, artemether injection was changed to artesunate (120 mg/day) for the reason that the plasmodium-infected red blood cells still can be found under the microscope (Figure 2). Noteworthy, even though the serological test of HTNV-IgM was still positive on the fifth day of admission, the typical stages of HFRS, including febrile, hypotension, oliguria, polyuria, or HTNV-IgG, were found, while the patient presented a progressive decline of erythrocytes and hemoglobin coupled with a symptom of anemia, which coincided with the characteristics of malaria (6). Thus, the patient was treated with artesunate for antimalaria, methylprednisolone, and meropenem for anti-infection, coupled with corresponding supportive treatment as mentioned above, until the 10th day of admission.
Figure 2
Different stages of Plasmodium falciparum presented in the peripheral blood of the patient. The ring of Plasmodium falciparum was found in the peripheral blood of the patient from the first day to the second day of admission (A), and later, trophozoite of Plasmodium falciparum was confirmed on the fifth day of hospitalization (B), followed by an emerging of gametophyte at the seventh day of hospitalization (C), and plasmodium cannot be found at the 10th day of admission, which is beneficial from a precise differential diagnosis and effective specific treatment (D).
After 13 days of hospitalization, major clinical values of the patient gradually returned to normal and were discharged from the hospital with no further discomfort. Given that his erythrocyte and hemoglobin levels were below normal, he was advised to monitor his condition and contact a clinician if he felt any discomfort.
3 Discussion
The world has witnessed a number of epidemics and pandemics that have taken thousands or millions of lives. Even with advances in diagnosis, monitoring, and treatment, we are still threatened by established and emerging pathogens. HFRS and malaria are among the disorders mentioned above. Although an increased effort has been made to elucidate the pathogenesis, and various measures have been applied to prevent, treat, and manage these disorders, the world has become aware of the profound influence of HFRS and malaria on public health (1, 3). Furthermore, owing to the similarities in multiple aspects shared by these disorders, it is a great challenge for clinicians to make a precise diagnosis and effective treatment timely.
The confusion in the differential diagnosis of these two disorders involves various factors, which first include similar symptoms of fever, fatigue, and thrombocytopenia. As presented herein, the patient suffered recurrent fever and a declining level of platelets with a nadir value of 18 × 109/L (normal range, 85–303 × 109/L), which can be both found in HFRS and malaria (1, 3), despite the fact that the mechanisms of thrombocytopenia in these two disorders may vary and remain to be elucidated. Second, the innate and adaptive immune responses involving the CD8+ T lymphocytes and NK cells toward HFRS and malaria are another issue that needs to be considered. As reported, immune-mediated mechanisms, in particular T cell activation in the acute phase, are associated with the pathogenesis of HFRS, and pathological damage induced by disorders of immune regulation may also contribute to the onset of HFRS (7–9). Meanwhile, a distinct change in the levels of NK cells, CD8+ T lymphocytes, was also observed in the HFRS patients, and the CD8+ T lymphocyte is considered to play a vital role in eliminating the Hantavirus (10, 11). In addition, malaria parasite-specific CD8+ T lymphocytes have been found in the blood of individuals living in endemic areas and after vaccination (12). Interestingly, NK cells have an influence on the generation and maintenance of productive CD8+ T lymphocyte responses and have also been documented to play a major role in the host response to virus infection. Besides, it has been demonstrated that NK cells contribute to the inhibition of parasite growth via the production of IFN-γ and are the first cells in peripheral blood in response to P. falciparum infection (13–15). Of note, abnormality of immune cells, including the CD8+ T lymphocytes and NK cells of the patient presented herein, was also found, which further demonstrated the significant role of immune response in the course of these two disorders, and the reversed CD4+ versus CD8+ T lymphocyte ratio observed herein, which is reported in Hantavirus-infected individuals, posed additional challenges for clinicians in differential diagnosis (16). Third, as presented in this paper, the patient suffered renal failure with an elevated level of Cr, urea, and UA; these symptoms and the corresponding mechanism are further cause for concern. As reported, the nephrotic syndrome caused by acute glomerulonephritis has been documented in patients with P. falciparum infection, and renal injury/failure, which is indicated by widespread capillary engorgement, focal hemorrhage, and interstitial edema, is also one hallmark of HFRS (1, 3, 17). Even though the pathogenesis is not completely understood, a large body of evidence has revealed that the endothelium is an important part of the underlying mechanisms. It has been documented that vascular endothelial cells are the primary targets of HTNV, and increasing vascular permeability is associated with various vascular adhesion molecules. Furthermore, the transformation of endothelial activation from a basic to a sticky state, which is advantageous for cell adhesion molecules binding, is considered to be an essential stage of renal injury caused by malaria (1, 3). Thus, the similarity shared by HFRS and malaria, including the symptoms, immune response, and underlying mechanism of renal injury/failure, has undoubtedly challenged the clinicians’ decision-making.
Fortunately, advances in supportive examination, particularly the development of imaging, the accumulation of clinical practice, and effective communication between the laboratory and clinical, have all made significant contributions to the differential diagnosis of various diseases. As reported herein, the patient presented a symptom of malaria coupled with a positive HTNV-IgM and was initially suspected to be a coinfection case in other medical institutions. However, because the IgM test can be influenced by various factors, including a vigorous immune response, vaccination, cross-reactivity, autoimmune diseases, heterologous reactions to similar viruses, naturally occurring biotin IgM antibodies, low pretest probability, and inappropriate test ordering, a misdiagnosis based on a single IgM test may go undetected (18). Meanwhile, the vital role of IgG in disease progression should be seriously considered because this antibody is dominant in the late phase of infection, and it also acts as a basis for ruling out the possibility of HTNV infection in this study because HTNV-IgG was never detected. Noteworthy, apart from the laboratory examination, we found that the patient had a history of travel to the Republic of Cameroon, which is an endemic area of malaria, rather than living in an endemic area of HFRS or having a history of exposure to the excreta of rodents. The HFRS infection generally occurs via the inhalation of hantavirus-contaminated aerosols from excretions, including urine, feces, and saliva (19, 20). Accordingly, the epidemiology indicated that the patient with no potential risk to HFRS infection which give us another reliable clue to get the truth. Furthermore, the patient did not present a course of HFRS such as hypotension, oliguria, and polyuria during the hospitalization but had a characteristic of malaria, including the progressed decline of erythrocytes and hemoglobin, which further demonstrated that the HTNV-IgM test is a false positive. Meanwhile, given the timepoint characteristics of HFRS prevalence, which generally emerge in winter (November to January) and early summer (May to July) (17), the patient presented herein complained of discomfort in September. Taken the information aforementioned together, the patient was preferred to be infected with malaria and treated with the corresponding antimalaria treatment. Meanwhile, the application of meropenem combined with supportive treatment in the deterioration condition reported herein greatly improved the status of the patient, which further demonstrated the advantages of this medicine in empirical therapy before the identification of causative organisms or for disease caused by single or multiple susceptible bacteria in both adults and children with a broad range of serious infections (21).
Admittedly, the case presented herein is rarely reported, and the patient was eventually getting a clear diagnosis, but there remain certain limitations. Specifically, given that this paper is a case report with limitations due to the magnitude of the study population and the absence of a control group, a large number of cases should be examined in the future to provide a powerful basis for clinicians in future clinical practice. Furthermore, since this report is a retrospective study, it posed a challenge for us to collect comprehensive and continuous medical data, even though it is inherent in case reports to some extent. Additionally, owing to the variety of methodologies such as the examination of HTNV, which can be confirmed by various methods including the enzyme-linked immunosorbent assay (ELISA), immunochromatographic (ICG) test, real-time reverse transcription-polymerase chain reaction (PCR), and Western blot (WB), as well as the variety in medicine application of the treatment, particularly the traditional Chinese medicine adopted in this study, which may not be approved or accepted out of China. Thus, the exploration of an analogous method of laboratory examination as well as medicine with similar efficacy for the disorder’s treatment is needed and would be beneficial for corresponding clinical differential diagnosis in nearing days.
4 Conclusion
Laboratory examinations, particularly the serological test, which is a convenient, less expensive, and time-saving method, play a key role in the supportive examinations. Nevertheless, given that the serological test can be influenced by various factors that may lead to misdiagnosis and delays in effective treatment, it is precise for clinicians to make a comprehensive decision based on a series of information collection methods involving the history of health, epidemiology, physical examination, and specific examinations that include the tests of conventional laboratory parameters and the well-accepted methods involving the ICG, real-time PCR, and WB. Considering that similar manifestations can be shared by disorders, differential diagnosis in clinical treatment not only depends on the well-acquainted characteristics of various diseases but also on the precise application of examinations.
Statements
Data availability statement
The original contributions presented in the study are included in the article/supplementary material, further inquiries can be directed to the corresponding author.
Ethics statement
The studies involving humans were approved by Shaanxi Provincial Hospital of Infectious Diseases (Eighth Affiliated Hospital of the Medical College of Xi’an Jiaotong University) Review Board. The studies were conducted in accordance with the local legislation and institutional requirements. The participants provided their written informed consent to participate in this study. Written informed consent was obtained from the individual(s) for the publication of any potentially identifiable images or data included in this article.
Author contributions
H-DZ: Data curation, Resources, Writing – original draft. H-BQ: Investigation, Supervision, Writing – original draft. Z-KW: Software, Writing – original draft, Resources. R-KR: Writing – original draft, Resources. T-BY: Methodology, Software, Writing – original draft. H-LL: Funding acquisition, Writing – review & editing.
Funding
The author(s) declare financial support was received for the research, authorship, and/or publication of this article. This work was supported by the National Natural Science Foundation of China (no. 81572435).
Conflict of interest
The authors declare that the research was conducted in the absence of any commercial or financial relationships that could be construed as a potential conflict of interest.
Publisher’s note
All claims expressed in this article are solely those of the authors and do not necessarily represent those of their affiliated organizations, or those of the publisher, the editors and the reviewers. Any product that may be evaluated in this article, or claim that may be made by its manufacturer, is not guaranteed or endorsed by the publisher.
References
1.
Heyman P Vaheri A Lundkvist A Avsic-Zupanc T . Hantavirus infections in Europe: from virus carriers to a major public-health problem. Expert Rev Anti-Infect Ther. (2009) 7:205–17. doi: 10.1586/14787210.7.2.205
2.
Yan L Fang LQ Huang HG Zhang LQ Feng D Zhao WJ et al . Landscape elements and Hantaan virus-related hemorrhagic fever with renal syndrome, People's Republic of China. Emerg Infect Dis. (2007) 13:1301–6. doi: 10.3201/Eid1309.061481
3.
Garcia LS . Malaria. Clin Lab Med. (2010) 30:93–129. doi: 10.1016/J.Cll.2009.10.001
4.
Milner DA Jr . Malaria pathogenesis. Cold Spring Harb Perspect Med. (2018) 8:a025569. doi: 10.1101/Cshperspect.A025569
5.
Sehgal A Mehta S Sahay K Martynova E Rizvanov A Baranwal M et al . Hemorrhagic fever with renal syndrome in Asia: history, pathogenesis, diagnosis, treatment, and prevention. Viruses. (2023) 15:561. doi: 10.3390/V15020561
6.
Moya-Alvarez V Bodeau-Livinec F Cot M . Iron and malaria: a dangerous liaison?Nutr Rev. (2016) 74:612–23. doi: 10.1093/Nutrit/Nuw021
7.
Huang C Jin B Wang M Li E Sun C . Hemorrhagic fever with renal syndrome: relationship between pathogenesis and cellular immunity. J Infect Dis. (1994) 169:868–70. doi: 10.1093/Infdis/169.4.868
8.
Kraus AA Raftery MJ Giese T Ulrich R Zawatzky R Hippenstiel S et al . Differential antiviral response of endothelial cells after infection with pathogenic and nonpathogenic hantaviruses. J Virol. (2004) 78:6143–50. doi: 10.1128/Jvi.78.12.6143-6150.2004
9.
Markotic A Dasic G Gagro A Sabioncello A Rabatic S Kuzman I et al . Role of peripheral blood mononuclear cell (Pbmc) phenotype changes in the pathogenesis of Haemorrhagic fever with renal syndrome (Hfrs). Clin Exp Immunol. (1999) 115:329–34. doi: 10.1046/J.1365-2249.1999.00790.X
10.
Xie M Dong Y Zhou Y Ren H Ji Y Lv S . Levels of Htnv-specific Cd8+ T lymphocytes in Pbmc from the patients with hemorrhagic fever with renal syndrome. Intern Emerg Med. (2013) 8:503–8. doi: 10.1007/S11739-011-0633-4
11.
Zhao HD Sun JJ Yu TB Liu HL . Predictive value of Cd4(+)Cd8(+) double positive T cells for the severity of hemorrhagic fever with renal syndrome. Clin Biochem. (2023) 120:110643. doi: 10.1016/J.Clinbiochem.2023.110643
12.
Romero P Maryanski JL Corradin G Nussenzweig RS Nussenzweig V Zavala F . Cloned cytotoxic T cells recognize an epitope in the Circumsporozoite protein and protect against malaria. Nature. (1989) 341:323–6. doi: 10.1038/341323a0
13.
Lodoen MB Lanier LL . Natural killer cells as an initial defense against pathogens. Curr Opin Immunol. (2006) 18:391–8. doi: 10.1016/J.Coi.2006.05.002
14.
Ryg-Cornejo V Nie CQ Bernard NJ Lundie RJ Evans KJ Crabb BS et al . Nk cells and conventional dendritic cells engage in reciprocal activation for the induction of inflammatory responses during plasmodium Berghei Anka infection. Immunobiology. (2013) 218:263–71. doi: 10.1016/J.Imbio.2012.05.018
15.
Wolf AS Sherratt S Riley EM . Nk cells: uncertain allies against malaria. Front Immunol. (2017) 8:212. doi: 10.3389/Fimmu.2017.00212
16.
Avsic-Zupanc T Saksida A Korva M . Hantavirus infections. Clin Microbiol Infect. (2019) 21:E6–E16. doi: 10.1111/1469-0691.12291
17.
Zou LX Chen MJ Sun L . Haemorrhagic fever with renal syndrome: literature review and distribution analysis in China. Int J Infect Dis. (2016) 43:95–100. doi: 10.1016/J.Ijid.2016.01.003
18.
Landry ML . Immunoglobulin M for acute infection: true or false?Clin Vaccine Immunol. (2016) 23:540–5. doi: 10.1128/Cvi.00211-16
19.
Bi Z Formenty PB Roth CE . Hantavirus infection: a review and global update. J Infect Dev Ctries. (2008) 2:3–23. doi: 10.3855/Jidc.317
20.
Jiang H Du H Wang LM Wang PZ Bai XF . Hemorrhagic fever with renal syndrome: pathogenesis and clinical picture. Front Cell Infect Microbiol. (2016) 6:1. doi: 10.3389/Fcimb.2016.00001
21.
Baldwin CM Lyseng-Williamson KA Keam SJ . Meropenem: a review of its use in the treatment of serious bacterial infections. Drugs. (2008) 68:803–38. doi: 10.2165/00003495-200868060-00006
Summary
Keywords
HFRS, Hantaan virus, malaria, false-positive IgM, case report
Citation
Zhao H-D, Qian H-B, Wang Z-K, Ren R-K, Yu T-B and Liu H-L (2024) Patient with suspected co-infection of hemorrhagic fever with renal syndrome and malaria: a case report. Front. Med. 11:1341015. doi: 10.3389/fmed.2024.1341015
Received
07 December 2023
Accepted
10 April 2024
Published
01 May 2024
Volume
11 - 2024
Edited by
Hong Du, Air Force Medical University, China
Reviewed by
Qingxia Zhao, Sixth People's Hospital of Zhengzhou, China
Hassan Alhassan, Al Jouf University, Saudi Arabia
Updates
Copyright
© 2024 Zhao, Qian, Wang, Ren, Yu and Liu.
This is an open-access article distributed under the terms of the Creative Commons Attribution License (CC BY). The use, distribution or reproduction in other forums is permitted, provided the original author(s) and the copyright owner(s) are credited and that the original publication in this journal is cited, in accordance with accepted academic practice. No use, distribution or reproduction is permitted which does not comply with these terms.
*Correspondence: Hong-Li Liu, liuhongli1965@163.com
Disclaimer
All claims expressed in this article are solely those of the authors and do not necessarily represent those of their affiliated organizations, or those of the publisher, the editors and the reviewers. Any product that may be evaluated in this article or claim that may be made by its manufacturer is not guaranteed or endorsed by the publisher.